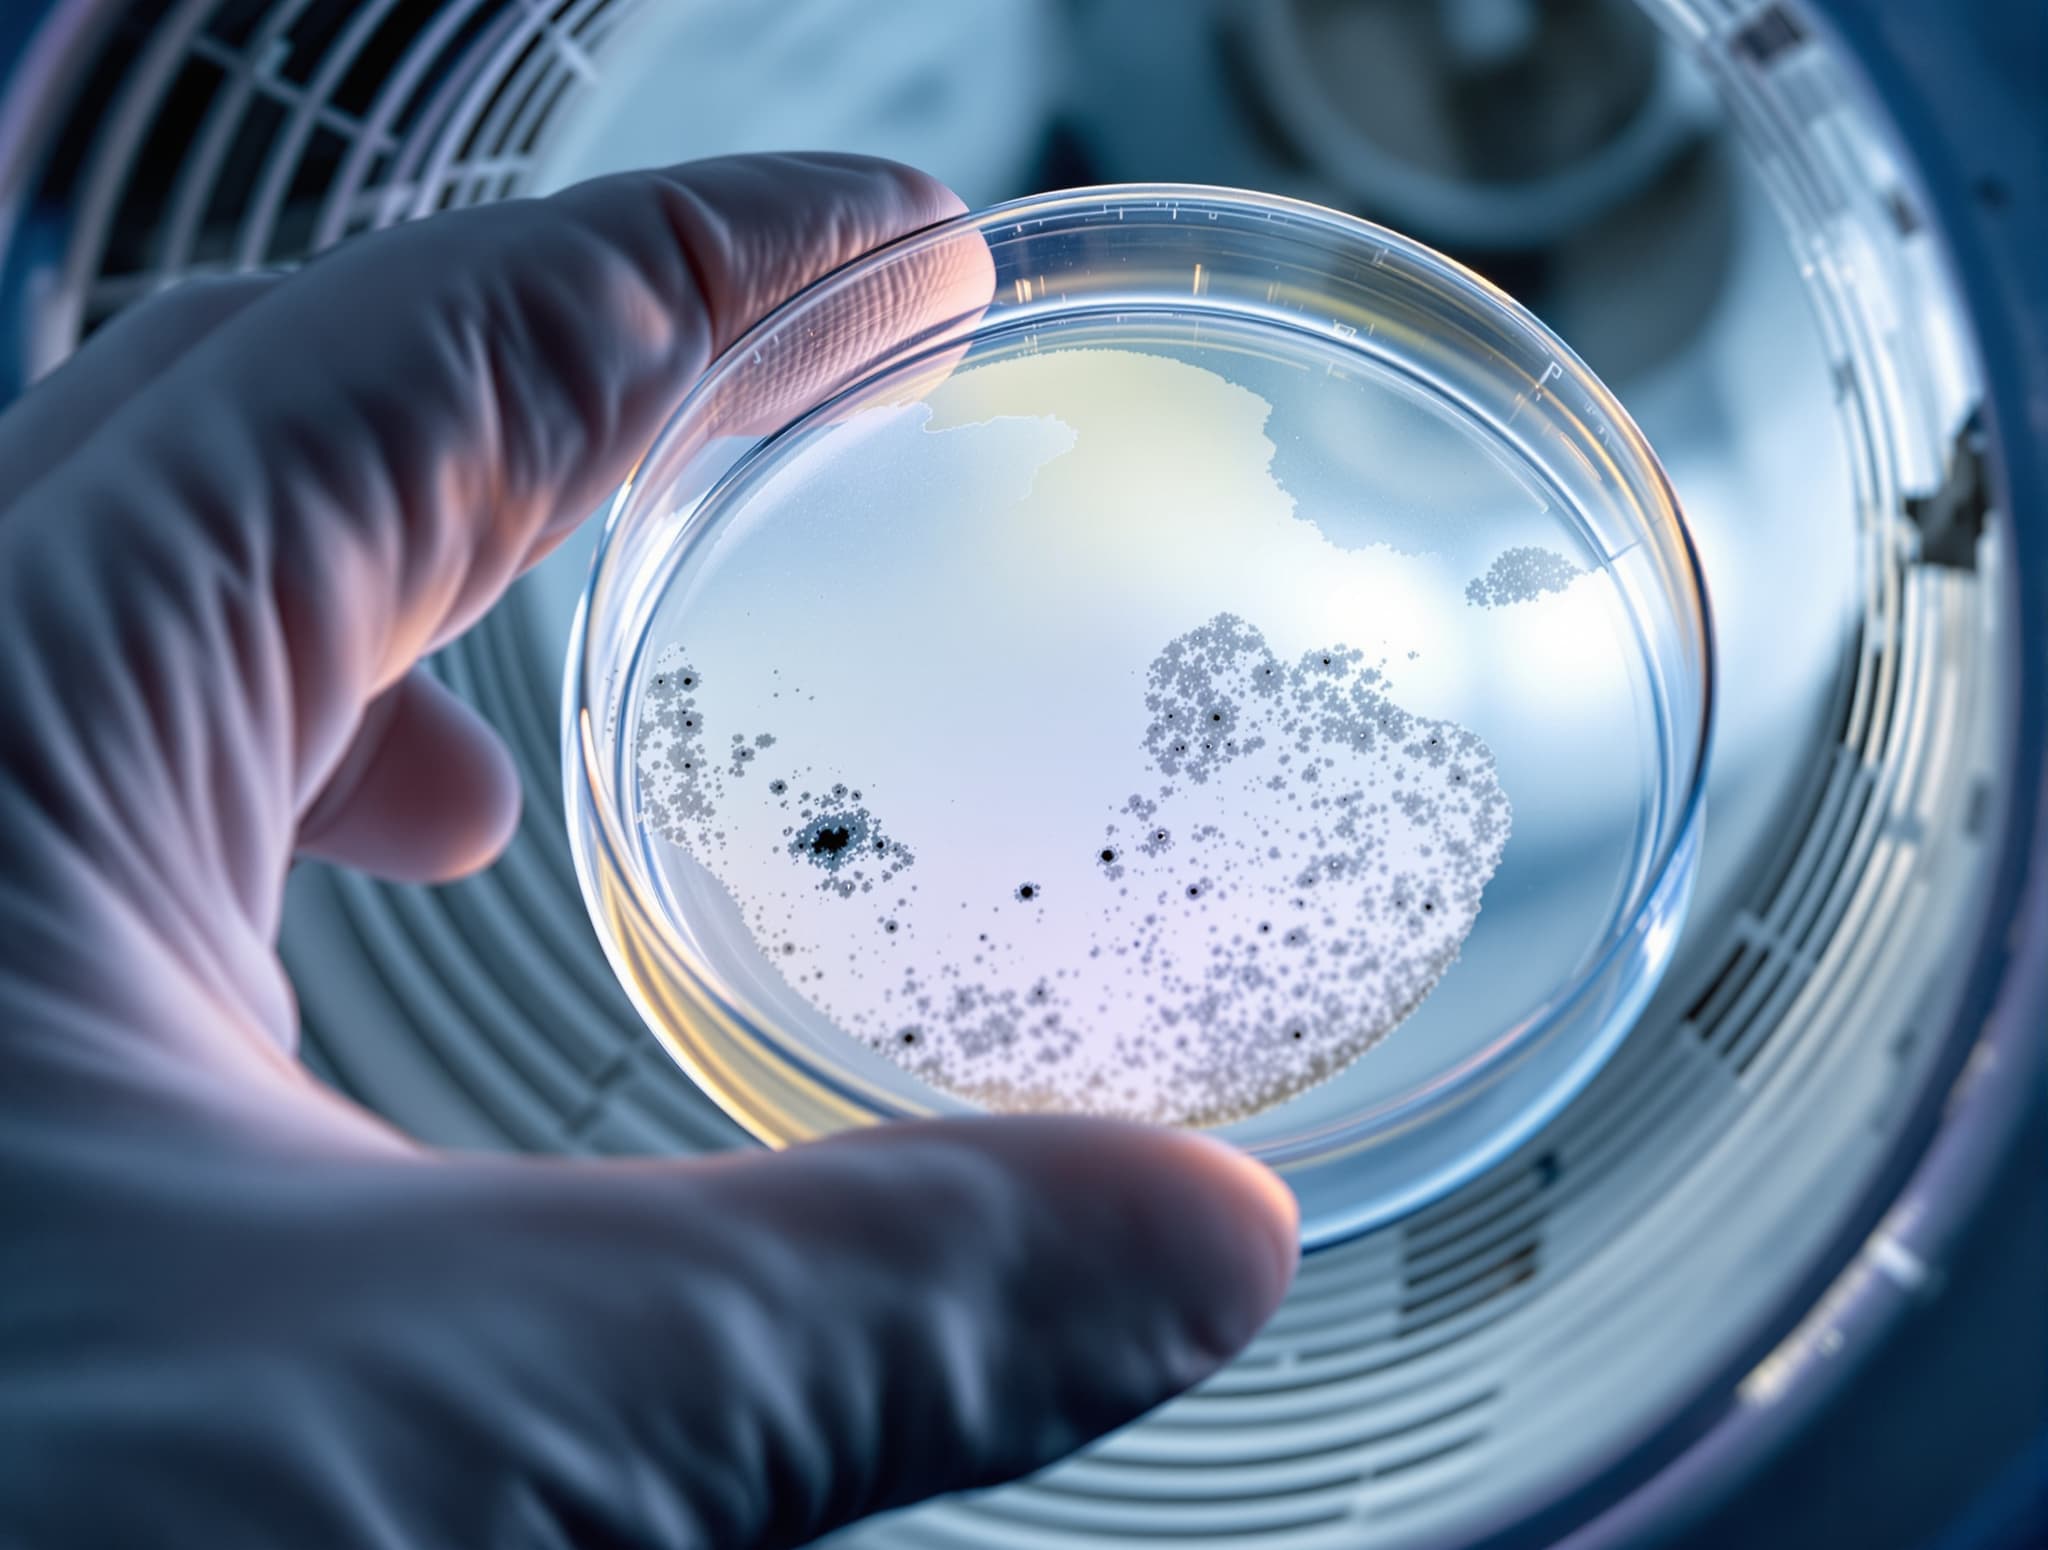
Mold Inspection

Full air duct cleaning on a 1960s split-level. 14 supply vents, 4 returns, 1 zone. Before-and-after camera scope showed 3 cubic feet of dust removed from the trunk line.
Every job we do gets photo and camera-scope documentation. Here's a recent sample.




Full air duct cleaning on a 1960s split-level. 14 supply vents, 4 returns, 1 zone. Before-and-after camera scope showed 3 cubic feet of dust removed from the trunk line.


NADCA-compliant HVAC system cleaning before property transfer inspection. Cleaned coils, blower wheel, and plenum on a 16-year-old Trane system.


Dryer vent cleaning after homeowner noticed longer drying times. Pulled 2.1 lb of lint from a 24-foot exterior run. Tested airflow at 3,400 fpm post-clean.


Mold-in-ducts inspection after finished basement water intrusion. Surface swabs sent to EMSL lab. Findings report delivered within 72 hours.


New construction duct cleaning on a custom colonial before owner move-in. Removed sheetrock dust, insulation particles, and sawdust from 22 supply lines.


Indoor air quality test on a 1990s bi-level with chronic allergy complaints. PM2.5 at 41 µg/m³ before cleaning, 12 µg/m³ after full duct and HVAC clean.


Commercial duct cleaning for a 3,800 sq ft dental practice in Nassau. After-hours service with NADCA written scope and lab-verified surface samples.


Full-system air duct cleaning including return trunk brush-out. Camera scope video archived to owner cloud folder as part of standard delivery.


Dryer vent cleaning and rigid-pipe conversion. Replaced 18 feet of foil-wrapped flex with smooth aluminum to eliminate lint snag points.


HVAC deep clean on a 2008 Lennox system. Cleaned evaporator coils, replaced media filter, and treated drain pan with EPA-registered antimicrobial.


Full-system air duct cleaning on a two-story colonial with 2 HVAC zones. Delivered 24-page NADCA-style report with before/after scope photos.


Commercial HVAC cleaning for an 11,500 sq ft medical office. Six rooftop units plus all supply trunks. Overnight service window.


Dryer vent cleaning on a condo with a 35-foot horizontal run. Pulled 3.4 lb of compacted lint. Recommended quarterly re-cleaning given length.


Mold-in-ducts inspection with air sampling cassettes. Aspergillus detected above background. Remediation scope written and coordinated with IICRC firm.


New construction duct cleaning on a custom waterfront build before CO inspection. 34 supply registers, 6 returns, 2 zones.


Indoor air quality test on a ranch home with a smoker history. VOC and particulate readings documented, ozone-free purifier recommendations provided.


Full air duct cleaning and HVAC deep clean combo. Homeowner had installed a new heat pump and wanted a clean slate. Two tech crew, full day.


Dryer vent cleaning after homeowner found scorch marks on the back of the appliance. Replaced crushed flex duct and added a wall-cap bird guard.


Commercial duct cleaning for a 6,200 sq ft Patchogue restaurant after a renovation. Coordinated timing with local health department re-opening inspection.


HVAC system deep clean on a 2004 American Standard unit. Blower wheel had 1/4 inch of caked dust, likely contributing to short-cycling.


Air quality calculator estimated $210/yr in HVAC savings on this job. Clean coils and ducts measured 18% improvement in CFM at registers.


Three neighboring homes booked on one week for a street-wide dryer vent cleaning sweep after a nearby dryer fire in town.


Large home full-system clean with 28 supply registers across three zones. 10-hour job, two-tech crew, camera scope documentation at each run.


Pre-listing duct cleaning for a waterfront home. Realtor included the written NADCA report in the listing to differentiate from comps.

Emergency dryer vent cleaning after a customer's load started smelling smoky. Full line cleared and vent cap replaced within 3 hours of the call.
Free on-site scope. You see your ducts on a tablet before we quote.
or fill out the form, it takes 20 seconds
Five fields. We take it from there.